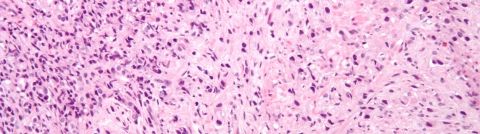
Dr. Douglas McNeel Co-Authors Guidelines for Prostate Cancer Immunotherapy

Dr. Douglas McNeel co-authors guidelines for prostate cancer immunotherapy
The first clinical guidelines for prostate cancer immunotherapy ever published were released in December, 2016 by an expert panel led by Douglas McNeel, MD, PhD, professor, Hematology and Medical Oncology and James Gulley, MD, PhD, senior investigator, National Cancer Institute. They are among a series of new clinical guidelines produced by the Society for the Immunotherapy of Cancer (SITC) to help physicians identify appropriate use of cancer immunotherapies, address practical clinical use issues specific to immune-based treatments, and provide expert panel recommendations.
Prostate cancer is the most commonly diagnosed malignancy in men in the United States, with over 180,000 cases diagnosed in 2016. While 5-year survival rates approach 100 percent for patients with newly diagnosed stage I through III prostate cancer, one-third of men with early-stage cancer will develop recurrence, often with metastatic disease. While prostate cancer usually responds to initial androgen deprivation therapy, eventual resistance is nearly universal; the disease can progress to metastatic castrate-resistant prostate cancer (mCRPC). Under the current clinical algorithm, immunotherapy is employed in the setting of asymptomatic mCRPC.
At present, the only approved immunotherapy approach for mCRPC is sipuleucel-T, which aims to stimulate an immune response to the prostate cancer-specific antigen prostatic acid phosphatase (PAP). To do so, each patient’s dendritic cells are isolated by leukapheresis and sent to the vaccine manufacturer, which cultures the cells with PAP linked to granulocyte-macrophage colony-stimulating factor. The dendritic cells are then infused. The McNeel et al guidelines provided consensuses on sequencing of sipuleucel-T with other therapies, monitoring response during treatment, and determining when to begin treatment.
Consensus recommendations in the guidelines included:
- Use of sipuleucel-T for treating patients with mCRPC earlier in the disease stage (Level B data support).
- Use of sipuleucel-T in the management of mCRPC prior to chemotherapy in the era of abiraterone and enzalutamide (Level A data support).
- Discussion on level of evidence to support sipuleucel-T in mCRPC, concluding that further evaluation is needed on mechanisms of action, degree of antigenic spread and long-term immune activation, identification of optimal patient and tumor characteristics, and identification of clinical endpoints that reflect clinical benefit.
- Clinical laboratory testing for selecting patients for use of sipuleucel-T by evaluating levels of prostate-specific antigen (PSA), complete blood count (CBC), and liver enzymes.
- Guidance on weaning off corticosteroids prior to sipuleucel-T treatment.
- Guidance on sequencing sipuleucel-T treatment relative to other therapies including androgen receptor-targeted agents, radium, and chemotherapy, as well as recommendations for repeat dosing of sipuleucel-T.
- Guidance on monitoring parameters following sipuleucel-T therapy.
- Discussion of the cost-to-value ratio of sipuleucel-T therapy.
Additionally, the guidelines discuss other forms of prostate cancer immunotherapy agents in advanced stages of clinical evaluation, such as the PSA-TRICOM vaccine.
“New immune-based therapies continue to be developed and are entering clinical practice. As many of these therapies are new to oncologists, and have unique considerations in terms of treatment and toxicity management, SITC has a major goal of educating physicians and providing best practice information,” said Dr. McNeel, noting that similar guidelines are under development for other cancer types and will continue to be updated as new therapies are approved.
Release of these guidelines capped off a very successful year for Dr. McNeel and members of his laboratory, who published a dozen research articles in 2016 (listed in Resources below).
Resources
- McNeel DG, Bander NH, Beer TM, Drake CG, Fong L, Harrelson S, Kantoff PW, Madan RA, Oh WK, Peace DJ, Petrylak DP, Porterfield H, Sartor O, Shore ND, Slovin SF, Stein MN, Vieweg J, and Gulley JL. (2016) “The Society for Immunotherapy of Cancer Consensus Statement on Tumor Immunotherapy for the Treatment of Prostate Carcinoma.” J ImmunoTherapy Cancer 4:92-103. (PMID: pending, PMCID: pending)
- Colluru VT and McNeel DG. (2016) “B lymphocytes as direct antigen-presenting cells for anti-tumor DNA vaccines.” Oncotarget (in press). (PMID: 27661128, PMCID: pending)
- England CG, Ehlerding EB, Hernandez R, Rekoske BT, Graves SA, Sun H, Liu G, McNeel DG, Barnhart TE, and Cai W. (2016) “Preclinical pharmacokinetics and biodistribution studies of 89Zr-labeled pembrolizumab.” J Nucl Med (in press) (PMID: 27493273, PMCID: pending)
- Colluru VT, Zahm CD, and McNeel DG. (2016) “Mini-intronic plasmid vaccination elicits tolerant LAG3+ CD8 T cells and inferior anti-tumor responses.” Oncoimmunology (in press). (PMID: 27853647, PMCID: PMC5087309)
- Bloom JE and McNeel DG. (2016) “SSX2 regulates focal adhesion but does not drive the epithelial to mesenchymal transition in prostate cancer.” Oncotarget (in press). (PMID: 27276714, PMCID: pending)
- Choueiri TK, Fishman M, Escudier B, McDermott DF, Drake CG, Kluger HM, Stadler WM, Perez-Gracia JL, McNeel DG, Curti BD, Harrison MR, Plimack ER, Appleman L, Fong L, Albiges L, Cohen LJ, Young TC, Chasalow SD, Ross-MacDonald P, Srivastava S, Jure-Kunkel M, Kurland JF, Simon JS, and Sznol M. (2016) “Immunomodulatory activity of nivolumab in metastatic renal cell carcinoma.” Clin Canc Res (in press). (PMID: 27169994, PMCID: PMC5106340)
- Rekoske BT, Olson BM, and McNeel DG. (2016) “Anti-tumor vaccination of prostate cancer patients elicits PD-1/PD-L1 regulated antigen-specific immune responses.” Oncoimmunology (in press). (PMID: 27471641, PMCID: PMC4938302)
- McNeel DG. (2016) “TCR diversity – A universal cancer immunotherapy biomarker?” J. ImmunoTherapy Cancer 4:69-72. (PMID: 27879971, PMCID: PMC5109785)
- Rekoske BT and McNeel DG. (2016) “Immunotherapy for Prostate Cancer: False Promises or True Hope?” Cancer (in press). (PMID: 27649312, PMCID: PMC5115970)
- Ehlerding EB, England CG, McNeel DG, and Cai W. (2016) “Molecular imaging of immunotherapy targets in cancer.” J. Nucl. Med. 57:1487-1492. (PMID: 27469363, PMCID: PMC5050107)
- Colluru VT, Johnson LE, Olson BM, and McNeel DG. (2016) “Preclinical and clinical development of DNA vaccines for prostate cancer.” Urol. Oncol. 34:193-204. (PMID: 24332642, PMCID: PMC4053490)
- Bradley ES and McNeel DG. “DNA Vaccines.” Marshall JL ed. Encyclopedia of Cancer Therapeutic Targets. New York: Springer, 2016.